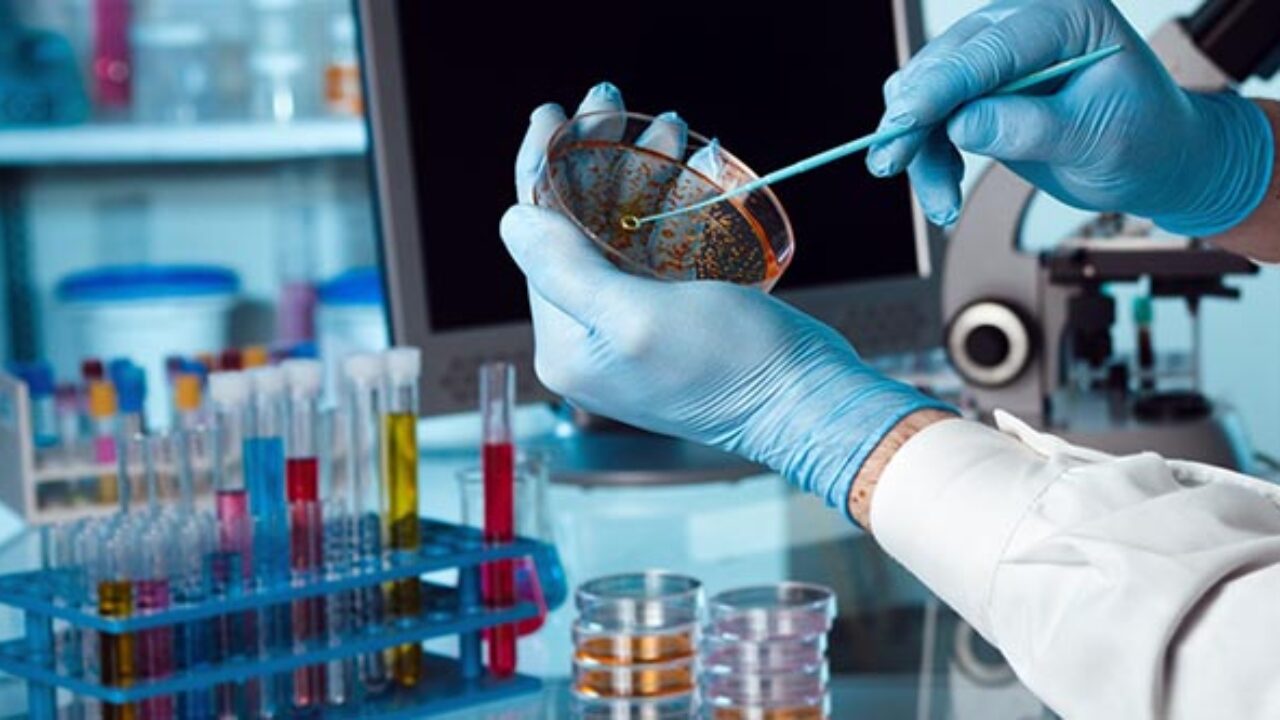
Biotecnologia.jpg

Conteúdo Programático:
- Conceito de biotecnologia
- Produtos de origem biotecnológica
- A Sociedade Brasileira de Biotecnologia
- Biodiversidade, biotecnologia e saúde
- Tecnologia baseada nas ciências biológicas
- Universalidade: bioquímica, células e o código genético
- Da biodiversidade à biotecnologia